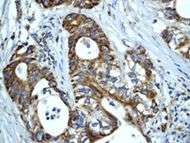

HSP60
| TCP-1/cpn60 chaperonin family | |||||||||
|---|---|---|---|---|---|---|---|---|---|
![]() Structure of the bacterial chaperonin GroEL.[1] | |||||||||
| Identifiers | |||||||||
| Symbol | Cpn60_TCP1 | ||||||||
| Pfam | PF00118 | ||||||||
| InterPro | IPR002423 | ||||||||
| PROSITE | PDOC00610 | ||||||||
| SCOP | 1grl | ||||||||
| SUPERFAMILY | 1grl | ||||||||
| |||||||||
Heat shock proteins are generally responsible for preventing damage to proteins in response to high levels of heat. Heat shock proteins are classified into six major families based on their molecular mass: small HSPs, HSP40, HSP60, HSP70, HSP90, and HSP110[2]
HSP60 is implicated in mitochondrial protein import and macromolecular assembly. It may facilitate the correct folding of imported proteins, and may also prevent misfolding and promote the refolding and proper assembly of unfolded polypeptides generated under stress conditions in the mitochondrial matrix. HSP60 interacts with HRAS and with HBV protein X and HTLV-1 protein p40tax. HSP60 belongs to the chaperonin (HSP60) family. Note: This description may include information from UniProtKB.
Alternate Names: 60 kDa chaperonin, Chaperonin 60, CPN60, Heat shock protein 60, HSP-60, HuCHA60, Mitochondrial matrix protein P1, P60 lymphocyte protein, HSPD1
Heat shock protein 60 (HSP60) is a mitochondrial chaperonin that is typically held responsible for the transportation and refolding of proteins from the cytoplasm into the mitochondrial matrix. In addition to its role as a heat shock protein, HSP60 functions as a chaperonin to assist in folding linear amino acid chains into their respective three-dimensional structure. Through the extensive study of groEL, HSP60’s bacterial homolog, HSP60 has been deemed essential in the synthesis and transportation of essential mitochondrial proteins from the cell's cytoplasm into the mitochondrial matrix. Further studies have linked HSP60 to diabetes, stress response, cancer and certain types of immunological disorders.
Discovery
Not much is known about the function of HSP60. Mammalian HSP60 was first reported as a mitochondrial P1 protein. It was subsequently cloned and sequenced by Radhey Gupta and coworkers.[3] The amino acid sequence showed a strong homology to GroEL. It was initially believed that HSP60 functioned only in the mitochondria and that there was no equivalent protein located in the cytoplasm. Recent discoveries have discredited this claim and have suggested that there is a recognizable difference between HSP60 in the mitochondria and in the cytoplasm.[4] A similar protein structure exists in the chloroplast of certain plants. This protein presence provides evidence for the evolutionary relationship of the development of the mitochondria and the chloroplast by means of endosymbiosis.[3]
Structure
Under normal physiological conditions, HSP60 is a 60 kilodalton oligomer composed of monomers that form a complex arranged as two stacked heptameric rings.[5] This double ring structure forms a large central cavity in which the unfolded protein binds via hydrophobic interactions.[6] This structure is typically in equilibrium with each of its individual components: monomers, heptamers, and tetradeceamers.[7] Recent studies have begun to suggest that in addition to its typical location in the mitochondria, HSP60 can also be found in the cytoplasm under normal physiological conditions.[4]
Each subunit of HSP60 has three domains: the apical domain, the equatorial domain, and the intermediate domain.[8] The equatorial domain contains the binding site for ATP and for the other heptameric ring. The intermediate domain binds the equatorial domain and the apical domain together.[8] The intermediate domain induces a conformational change when ATP is bound allowing for an alternation between the hydrophilic and hydrophobic substrate binding sites.[8] In its inactive state, the protein is in a hydrophobic state. When activated by ATP, the intermediate domain undergoes a conformational change that exposes the hydrophilic region. This insures fidelity in protein binding.[8] Chaperonin 10 aids HSP60 in folding by acting as a dome-like cover on the ATP active form of HSP60. This causes the central cavity to enlarge and aids in protein folding.[8] See the above figure for further detail on the structure.


The mitochondrial HSP60 sequence contains a series of G repeats at the C-terminal.[3] The structure and function of this sequence is not quite known. The N-terminal contains a pre-sequence of hydroxylated amino acids, namely arginine, lysine, serine, and threonine, which serve as directors for the importation of the protein into the mitochondria.[3]
The predicted structure of HSP60 includes several vertical sine waves, alpha helices, beta sheets, and 90 degree turns. There are regions of hydrophobicity where the protein presumably spans the membrane. There are also three N-linked glycosylation sites at positions 104, 230, 436.[6] The sequence and secondary structure for the mitochondrial protein are illustrated in the above image obtained from the Protein Data Bank.
Newer information has begun to suggest that the HSP60 found in the mitochondria differs from that of the cytoplasm. With respect to the amino acid sequence, the cytoplasmic HSP60 has an N-terminal sequence not found in the mitochondrial protein.[4] In gel electrophoresis analysis, significant differences were found in the migration of cytoplasmic and mitochondrial HSP60. The cytoplasmic HSP60 contains a signal sequence of 26 amino acids on the N terminus. This sequence is highly degenerate and is capable of folding into amphiphilic helix.[4] Antibodies against HSP60 targeted both the mitochondrial and cytoplasmic form.[4] Nonetheless, antibodies against the signal sequence targeted only the cytoplasmic form. Under normal physiological condition, both are found in relatively equal concentrations.[4] In times of stress or high need of HSP60 in either the cytoplasm or the mitochondria, the cell is capable for compensating by increasing the presence of HSP60 in one compartment and decreasing its concentration in the opposite compartment.
Function
Common
Heat shock proteins are amongst the most evolutionarily conserved of proteins.[7] The significant function, structural, and sequential homology between HSP60 and its prokaryotic homolog, groEL, demonstrates this level of conservation. Moreover, HSP60’s amino acid sequence bears a similarity to its homolog in plants, bacteria, and humans.[2] Heat shock proteins are primarily responsible for maintaining the integrity of cellular proteins particularly in response to environmental changes. Stresses such as temperature, concentration imbalance, pH change, and toxins can all induce heat shock proteins to maintain the conformation of the cell’s proteins. HSP60 aids in the folding and conformation maintenance of approximately 15-30% of all cellular proteins.[8] In addition to HSP60’s typical role as a heat shock protein, studies have shown that HSP60 plays an important role in the transport and maintenance of mitochondrial proteins as well as the transmission and replication of mitochondrial DNA.
Mitochondrial protein transport
HSP60 possesses two main responsibilities with respect to mitochondrial protein transport. It functions to catalyze the folding of proteins destined for the matrix and maintains protein in an unfolded state for transport across the inner membrane of the mitochondria.[10] Many proteins are targeted for processing in the matrix of the mitochondria but then are quickly exported to other parts of the cell. The hydrophobic portion HSP60 is responsible for maintaining the unfolded conformation of the protein for transmembrane transport.[10] Studies have shown how HSP60 binds to incoming proteins and induces conformational and structural changes. Subsequent changes in ATP concentrations hydrolyze the bonds between the protein and HSP60 which signals the protein to exit the mitochondria.[10] HSP60 is also capable of distinguishing between proteins designated for export and proteins destined to remain in the mitochondrial matrix by looking for an amphiphilic alpha-helix of 15-20 residues.[10] The existence of this sequence signals that the protein is to be exported while the absence signals that the protein is to remain in the mitochondria. The precise mechanism is not yet entirely understood.
DNA Metabolism
In addition to its critical role in protein folding, HSP60 is involved in the replication and transmission of mitochondrial DNA. In extensive studies of HSP60 activity in Saccharomyces cerevisiae, scientists have proposed that HSP60 binds preferentially to the single stranded template DNA strand in a tetradecamer like complex [11] This tetradecamer complex interacts with other transcriptional elements to serve as a regulatory mechanism for the replication and transmission of mitochondrial DNA. Mutagenic studies have further supported HSP60 regulatory involvement in the replication and transmission of mitochondrial DNA.[12]Mutations in HSP60 increase the levels of mitochondrial DNA and result in subsequent transmission defects.
Cytoplasmic vs mitochondrial HSP60
In addition to the already illustrated structural differences between cytoplasmic and mitochondrial HSP60, there are marked functional differences. Studies have suggested that HSP60 plays a key role in preventing apoptosis in the cytoplasm. The cytoplasmic HSP60 forms a complex with proteins responsible for apoptosis and regulates the activity of these proteins.[4] The cytoplasmic version is also involved in immune response and cancer.[4] These two aspects will be elaborated on later. Extremely recent investigations have begun to suggest a regulatory correlation between HSP60 and the glycolytic enzyme, 6-phosphofructokinase-1. Although not much information is available, cytoplasmic HSP60 concentrations have influenced the expression of 6-phosphofructokinase in glycolysis.[13] Despite these marked differences between the cytoplasmic and mitochondrial form, experimental analysis has shown that the cell is quickly capable of moving cytoplasmic HSP60 into the mitochondria if environmental conditions demand a higher presence of mitochondrial HSP60.[4]
Synthesis and assembly
HSP60 is typically found in the mitochondria and has been found in organelles of endosymbiotic origin. HSP60 monomers form two heptameric rings that bind to the surface of linear proteins and catalyze their folding in an ATP dependent process.[14] HSP60 subunits are encoded by nuclear genes and translated into the cytosol. These subunits then move into the mitochondria where they are processed by other HSP60 molecules.[6] Several studies have shown how HSP60 proteins must be present in the mitochondria for the synthesis and assembly of additional HSP60 components.[6] There is a direct positive correlation between the presence of HSP60 proteins in the mitochondria and the production of additional HSP60 protein complexes.
The kinetics of assembly of HSP60 subunits into the 2-heptameric rings takes two minutes. The subsequent protease-resistant HSP60 is formed in a half-time of 5–10 minutes.[6] This rapid synthesis indicates that there is an ATP-dependent interaction where the formed HSP60 complex stabilizes the intermediate of the HSP60 assembly complex, effectively serving as a catalyst.[6] The necessity of preexisting HSP60 in order to synthesize additional HSP60 molecules supports the endosymbiotic theory of the origin of mitochondria. There must have been a rudimentary prokaryotic homologous protein that was capable of similar self-assembly.
Immunological role
As discussed above, HSP60 has generally been known as a chaperonin which assists in protein folding in mitochondria. However, some new research has indicated that HSP60 possibly plays a role in a “danger signal cascade” immune response.[15] There is also mounting evidence that it plays a role in autoimmune disease.
Infection and disease are extremely stressful on the cell. When a cell is under stress, it naturally increases the production of stress proteins, including heat shock proteins such as HSP60. In order for HSP60 to act as a signal it must be present in the extracellular environment. In recent research “it has emerged that…chaperonin 60 can be found on the surface of various prokaryotic and eukaryotic cells, and can even be released from cells”.[8] According to recent research, many different types of heat shock proteins are used in immune response signaling, but it appears that different proteins act and respond differently to other signaling molecules. HSP60 has been shown to be released from specific cells like peripheral blood mononuclear cells (PBMCs) when there are lipopolysaccharides (LPS) or GroEL present. This suggests that the cell has different receptors and responses to human and bacterial HSP60.[15] In addition, it has been shown that HSP60 has the capability “of activating monocytes, macrophages and dendritic cells…and also of inducing secretion of a wide range of cytokines.” [15] The fact that HSP60 responds to other signal molecules like LPS or GroEL and has the ability to activate certain types of cells supports the idea that HSP60 is part of a danger signal cascade which is involved in activating an immune response.
There is however, a twist in the immunological role of HSP60. As mentioned above, there are two different types of HSP60 proteins, bacterial as well as mammalian. Since they are very similar in sequence, bacterial HSP60 wouldn’t be expected to cause a large immune response in humans. The immune system is “designed to ignore ‘self’, that is, host constituents; however, paradoxically, this is not the case with chaperonins”.[8] It has been found that many anti-chaperonin antibodies exist and are associated with many autoimmune diseases. According to Ranford, et al. experiments have been performed which have shown that antibodies which are “generated by a human host after exposure to bacterial chaperonin 60 proteins” can cross-react with human chaperonin 60 proteins.[8] Bacterial HSP60 is causing the immune system to create anti-chaperonin antibodies, even though bacterial and human HSP60 have similar protein sequences. These new antibodies are then recognizing and attacking human HSP60 which causes an autoimmune disease. This suggests that HSP60 may play a role in autoimmunity, however more research needs to be done in order to discover more completely its role in this disease.
Stress response
HSP60, as a mitochondrial protein, has been shown to be involved in stress response as well. The heat shock response is a homeostatic mechanism that protects a cell from damage by upregulating the expression of genes that code for HSP60.[16] The upregulation of HSP60 production allows for the maintenance of other cellular processes occurring in the cell, especially during stressful times. In one experiment, investigators treated various mice with L-DOPA and discovered significant upregulation of HSP60 expression in the mitochondria and HSP70 expression in the cytoplasm. Researchers concluded that the heat shock signal pathway serves as “the basic mechanism of defense against neurotoxicity elicited by free radical oxygen and nitrogen species produced in aging and neurodegenerative disorders”.[17] Several studies have shown that HSP60 and other heat shock proteins are necessary for cellular survival under toxic or stressful circumstances.[18]
Relationship to cancer
Human Hsp60, the product of the HSPD1 gene, is a Group I mitochondrial chaperonin, phylogenetically related to bacterial GroEL. Recently, the presence of Hsp60 outside the mitochondria and outside the cell, e.g. in circulating blood, has been reported [1], [2]. Although it is assumed that Hsp60 extra-mitochondrial molecule is identical to the mitochondrial one, this has not yet been fully elucidated. Despite the increasing amount of experimental evidences showing Hsp60 outside the cell, it is not yet clear how general this process is and what are the mechanisms responsible for Hsp60 translocation outside the cell. Neither of these questions has been definitively answered, whereas there is some information regarding extracellular Hsp70. This chaperone was also classically regarded as an intracellular protein like Hsp60, but in the last few years considerable evidences showed its pericellular and extracellular residence
HSP60 has been shown to influence apoptosis in tumor cells which seems to be associated with a change in expression levels. There is some inconsistency in that some research shows a positive expression while other research shows a negative expression, and it seems to depend on the type of cancer. There are different hypotheses to explain the effects of positive versus negative expression. Positive expression seems to inhibit “apoptotic and necrotic cell death” while negative expression is thought to play a part “in activation of apoptosis”.[19][20]
As well as influencing apoptosis, HSP60 changes in expression level have been shown to be “useful new biomarkers for diagnostic and prognostic purposes.” [19] According to Lebret et al., a loss of HSP60 expression “indicates a poor prognosis and the risk of developing tumor infiltration” specifically with bladder carcinomas, but that does not necessarily hold true for other types of cancers.[21] For example, ovarian tumors research has shown that over expression is correlated with a better prognosis while a decreased expression is correlated with an aggressive tumor.[21] All this research indicates that it may be possible for HSP60 expression to be used in predicting survival for certain types of cancer and therefore may be able to identify patients who could benefit from certain treatments.[20]
References
- ↑ Braig K, Otwinowski Z, Hegde R, et al. (October 1994). "The crystal structure of the bacterial chaperonin GroEL at 2.8 A". Nature. 371 (6498): 578–86. doi:10.1038/371578a0. PMID 7935790.
- 1 2 Johnson RB, et al. (2003). "Cloning and characterization of the yeast chaperonin HSP60 gene". Genetics. 84: 295–300. doi:10.1016/0378-1119(89)90503-9. PMID 2575559.
- 1 2 3 4 Gupta RS (January 1995). "Evolution of the chaperonin families (Hsp60, Hsp10 and Tcp-1) of proteins and the origin of eukaryotic cells". Mol. Microbiol. 15 (1): 1–11. doi:10.1111/j.1365-2958.1995.tb02216.x. PMID 7752884.
- 1 2 3 4 5 6 7 8 9 Itoh H, Komatsuda A, Ohtani H, et al. (December 2002). "Mammalian HSP60 is quickly sorted into the mitochondria under conditions of dehydration". Eur. J. Biochem. 269 (23): 5931–8. doi:10.1046/j.1432-1033.2002.03317.x. PMID 12444982.
- ↑ Cheng MY, Hartl FU, Horwich AL (November 1990). "The mitochondrial chaperonin hsp60 is required for its own assembly". Nature. 348 (6300): 455–8. doi:10.1038/348455a0. PMID 1978929.
- 1 2 3 4 5 6 Fenton WA, et al. (October 1994). "Residues in chaperonin GroEL required for polypeptide binding and release". Nature. 371: 614–9. doi:10.1038/371614a0. PMID 7935796.
- 1 2 Habich C, et al. (March 2007). "Heat shock protein 60: regulatory role on innate immune cells". Cell. Mol. Life Sci. 64: 742–51. doi:10.1007/s00018-007-6413-7. PMID 17221165.
- 1 2 3 4 5 6 7 8 9 Ranford JC, et al. (September 2000). "Chaperonins are cell-signalling proteins: the unfolding biology of molecular chaperones". Expert Rev Mol Med. 2: 1–17. doi:10.1017/S1462399400002015. PMID 14585136.
- ↑ PDB: 1SRV; Walsh MA, et al. (June 1999). "Taking MAD to the extreme: ultrafast protein structure determination". Acta Crystallogr. D. 55: 1168–73. doi:10.1107/S0907444999003698. PMID 10329779.
- 1 2 3 4 Koll H, et al. (March 1992). "Antifolding activity of hsp60 couples protein import into the mitochondrial matrix with export to the intermembrane space". Cell. 68: 1163–75. doi:10.1016/0092-8674(92)90086-R. PMID 1347713.
- ↑ Kaufman, BA. Studies on mitochondria DNA nucleoids in Saccharomyces cerevisia: identification of bifunctional proteins. In Genetics and Development, UT Southwestern Medical Center at Dallas, Dallas, TX. 241pp.
- ↑ Kaufman, B. A. (2003). "A function for the mitochondrial chaperonin Hsp60 in the structure and transmission of mitochondrial DNA nucleoids in Saccharomyces cerevisiae". The Journal of Cell Biology. 163 (3): 457–461. doi:10.1083/jcb.200306132. ISSN 0021-9525. PMC 2173642
. PMID 14597775. - ↑ Koll H, et al. (1992). "Antifolding Activity of HSP60 Couples Protein Import into the Mitochondrial Matrix with Export to the Intermembrane Space". Cell. 68 (6): 1163–75. doi:10.1016/0092-8674(92)90086-R. PMID 1347713.
- ↑ Itoh H, et al. (December 2002). "Mammalian HSP60 is quickly sorted into the mitochondria under conditions of dehydration". European J. Biochem. 269: 5931–8. doi:10.1046/j.1432-1033.2002.03317.x. PMID 12444982.
- 1 2 3 Hansen JJ, Bross P, Westergaard M, et al. (January 2003). "Genomic structure of the human mitochondrial chaperonin genes: HSP60 and HSP10 are localised head to head on chromosome 2 separated by a bidirectional promoter". Hum. Genet. 112 (1): 71–7. doi:10.1007/s00439-002-0837-9. PMID 12483302.
- ↑ Vargas-Parada L, Solis C (2001). "Heat Shock and stress response of Taenia solium and T. crassiceps". Parasitology. 122: 583–8. doi:10.1017/s0031182001007764.
- ↑ Calabrese V, Mancuso C, Ravagna A, et al. (May 2007). "In vivo induction of heat shock proteins in the substantia nigra following L-DOPA administration is associated with increased activity of mitochondrial complex I and nitrosative stress in rats: regulation by glutathione redox state". J. Neurochem. 101: 709–17. doi:10.1111/j.1471-4159.2006.04367.x. PMID 17241115.
- ↑ Rossi MR, Somji S, Garrett SH, Sens MA, Nath J, Sens DA (December 2002). "Expression of hsp 27, hsp 60, hsc 70, and hsp 70 stress response genes in cultured human urothelial cells (UROtsa) exposed to lethal and sublethal concentrations of sodium arsenite". Environ. Health Perspect. 110: 1225–32. doi:10.1289/ehp.021101225. PMC 1241110
. PMID 12460802. - 1 2 Cappello F, Di Stefano A, David S, et al. (November 2006). "Hsp60 and Hsp10 down-regulation predicts bronchial epithelial carcinogenesis in smokers with chronic obstructive pulmonary disease". Cancer. 107 (10): 2417–24. doi:10.1002/cncr.22265. PMID 17048249.
- 1 2 Urushibara M, Kageyama Y, Akashi T, et al. (January 2007). "HSP60 may predict good pathological response to neoadjuvant chemoradiotherapy in bladder cancer". Jpn. J. Clin. Oncol. 37 (1): 56–61. doi:10.1093/jjco/hyl121. PMID 17095522.
- 1 2 Lebret T, Watson RW, Molinié V, et al. (September 2003). "Heat shock proteins HSP27, HSP60, HSP70, and HSP90: expression in bladder carcinoma". Cancer. 98 (5): 970–7. doi:10.1002/cncr.11594. PMID 12942564.
External links
- NIH Material on HSP60
- HSP60
- HSP60 in Flies
- The Chaperonin Home Page
- The Protein Data Bank
- Enzyme Database on HSP60
- HSP60 on Pub Med
- HSP60 Gene Report
- HSP60 Heat-Shock Proteins at the US National Library of Medicine Medical Subject Headings (MeSH)
